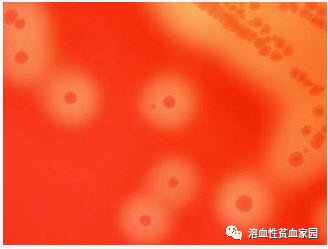
认识检查|血浆游离血红蛋白测定 认识检查|血浆游离血红蛋白测定

欢迎转载,转载请标明出处“溶血性贫血家园”💮💮

![]()
在小小的红细胞里挖呀挖呀挖
有小小的血红蛋白
送氧全靠它~

相信许多病友都做过血浆游离血红蛋白测定的检查。血红蛋白一般存在于红细胞里,那为什么会出现在血浆中?血红蛋白测定又有什么意义?本期认识检查就带大家来了解一下吧~

图源:百度
一
血红蛋白是什么?
成熟红细胞中主要蛋白质为血红蛋白,生理状态时血红蛋白存在于红细胞中。血红蛋白是红细胞内运输氧的特殊蛋白质,是使血液呈红色的蛋白,由珠蛋白和血红素组成。
二
血浆游离血红蛋白测定
血浆游离血红蛋白测定,指测定血浆中血红蛋白的量。当红细胞破坏,如发生溶血时,血红蛋白释放入血,于是导致血浆内游离血红蛋白增多。
图源:百度
三
血浆游离血红蛋白测定的指标
正常值:类过氧化物酶反应法<40mg/L (<4mg/dl)。不同检测方法以及不同检测器材正常参考值也不同,以您手中检查单为准。
四
血浆游离血红蛋白测定对溶贫患者的意义
血浆游离血红蛋白的增加是血管内溶血的指征,发生血管内溶血时血浆游离血红蛋白数值大于参考值。测定血浆游离血红蛋白可判断红细胞的破坏程度。

血浆游离血红蛋白升高:
血浆游离血红蛋白正常:

声明丨本文中涉及的内容信息仅用作疾病知识参考和学习,如需获得治疗方案指导,请前往正规医院就诊!


扫码加入溶贫病友群
咨询和交流溶血性贫血(HA)相关问题

点分享

点收藏

点点赞

点在看

